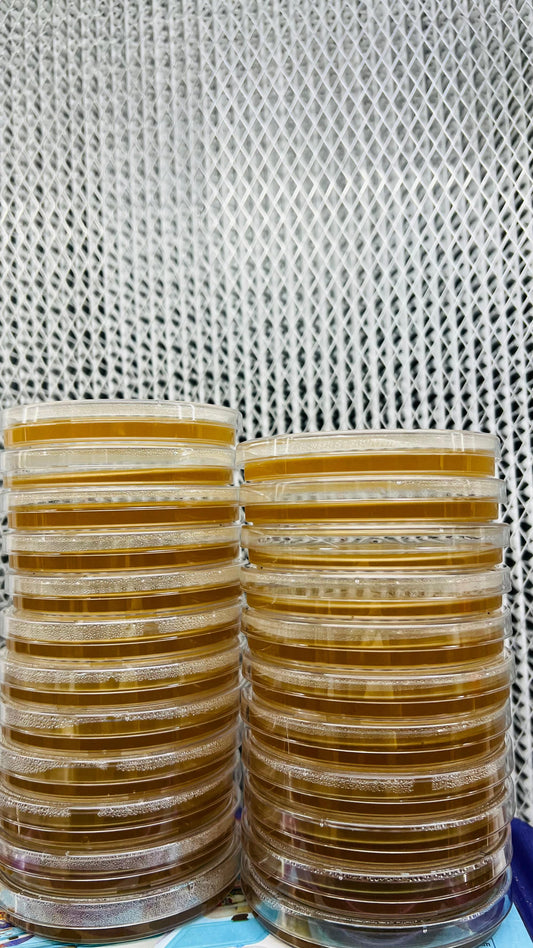

-
Mush Pellets Improved - Premium mushroom grow medium for Wood loving species
Regular price From Rs. 999.00Regular priceUnit price perRs. 10,000.00Sale price From Rs. 999.00Sale -
Mushroom Grow Bag All-In-One Dung loving Mushroom Grow Bag 1.25KG
Regular price Rs. 699.00Regular priceUnit price perRs. 999.00Sale price Rs. 699.00Sale -
25 block Oyster Mushroom growing combo + Master mix - Make 25 bags of 2.5KG each
Regular price From Rs. 2,090.00Regular priceUnit price perSale price From Rs. 2,090.00 -
Premium Five Layer Filter Patch Bag - Size 12x18 (56 Micron) 5 bags
Regular price Rs. 199.00Regular priceUnit price perRs. 450.00Sale price Rs. 199.00Sale -
Starter Mushroom grow Kit
Regular price From Rs. 490.00Regular priceUnit price perRs. 900.00Sale price From Rs. 490.00Sale -
Sterilized grain bag 1KG 100% with autoclave injection port
Regular price Rs. 799.00Regular priceUnit price perRs. 1,500.00Sale price Rs. 799.00Sold out -
Myco Mix Coir and compost-Based Sterile Mushroom Bulk Substrate - 1KG
Regular price Rs. 299.00Regular priceUnit price perRs. 600.00Sale price Rs. 299.00Sale -
Premium Mushroom Spawn - First Generation
Regular price From Rs. 65.00Regular priceUnit price perRs. 140.00Sale price From Rs. 65.00Sale -
PP gusseted cover - 25 pcs
Regular price Rs. 150.00Regular priceUnit price perRs. 150.00Sale price Rs. 150.00 -
SaleSAB - Still Air Box
Regular price Rs. 2,499.00Regular priceUnit price perRs. 3,500.00Sale price Rs. 2,499.00Sale -
Sold outPrepoured agarplates
Regular price Rs. 999.00Regular priceUnit price perRs. 1,500.00Sale price Rs. 999.00Sold out -
Premium Mushroom culture
Regular price From Rs. 1,499.00Regular priceUnit price perRs. 3,000.00Sale price From Rs. 1,499.00Sale -
SHROOMVILLA - Automated Mushroom Grow Tent (Pre-Order)
Regular price Rs. 21,999.00Regular priceUnit price perRs. 30,000.00Sale price Rs. 21,999.00Sale -
Sold out
Liquid Cultures
Regular price Rs. 1,200.00Regular priceUnit price perSale price Rs. 1,200.00Sold out -
MushPellets MastersMix - Premium mushroom grow medium for Wood loving species
Regular price From Rs. 1,725.00Regular priceUnit price perSale price From Rs. 1,725.00 -
Milky 25 block Mushroom growing combo - Make 25 bags of 2.5KG each
Regular price From Rs. 2,499.00Regular priceUnit price perSale price From Rs. 2,499.00Sold out -
Mush Pellets 2 KG - Premium mushroom grow medium for Wood loving species
Regular price Rs. 179.00Regular priceUnit price perSale price Rs. 179.00 -
Mush pellets Milky - 2 KG
Regular price Rs. 199.00Regular priceUnit price perSale price Rs. 199.00 -
MushPellets MastersMix 2 KG - Premium mushroom grow medium for Wood loving species
Regular price Rs. 299.00Regular priceUnit price perSale price Rs. 299.00 -
25 block Oyster Mushroom growing combo - Make 25 bags of 2.5KG each for Starters
Regular price From Rs. 1,999.00Regular priceUnit price perSale price From Rs. 1,999.00